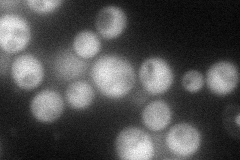
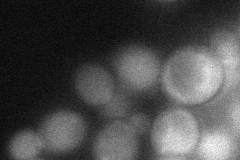
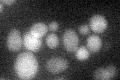

View description
Alcohol dehydrogenase isoenzyme V; involved in ethanol production
Localization:
Intensity:
Fold change:
Significance:
-
C’ GFP library in SD

cytosol39.58 -
N' NOP1pr-GFP in SD
cytosol85.341 -
N' TEF2pr-mCherry in SD

cytosol73.2221 -
N' NATIVEpr-GFP in SD

cytosol34.1849 -
N' TEF2pr-VC and Cyto-VN in SD
cytosol44.9794 -
C’ GFP library in SD+DTT

cytosol21.380.54No -
C’ GFP library in SD+H2O2

cytosol40.881.03No -
C’ GFP library in Starvation Media
cytosol34.780.87No -
C’ GFP library on the background of Pup2-DaMP

cytosol -
C’ GFP library on the background of CCT mutant

cytosol31.02420.783788No
